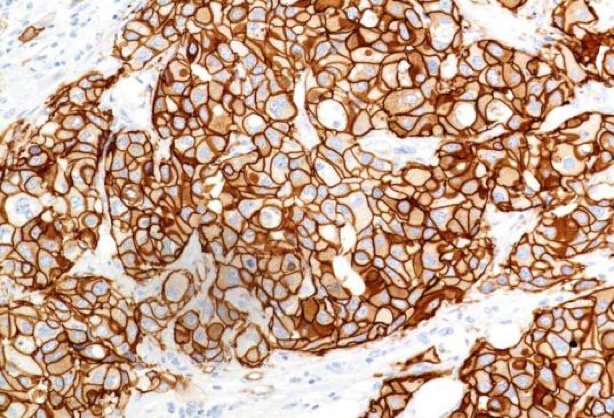
🔬 Roger Hunt banner

@Nate_path Did you reply “Are you ok, hun?”
Seems like there are issues there 🤷🏼♂️
English
🔬 Roger Hunt
1.1K posts

@doctorpath
Histopathologist in Manchester @MFTnhs Prof at @MMU_LifeScience ♥️ cheese, hockey, football @rogerhunt21






















1/ A thread about annual allowance in 21/22👇 [+ new free tool] Many will have received a nasty brown envelope from @nhs_pensions this week. If you have (and even if you haven't) you may need to take action. Pay attention and share (please RT) with colleagues who may need this!







